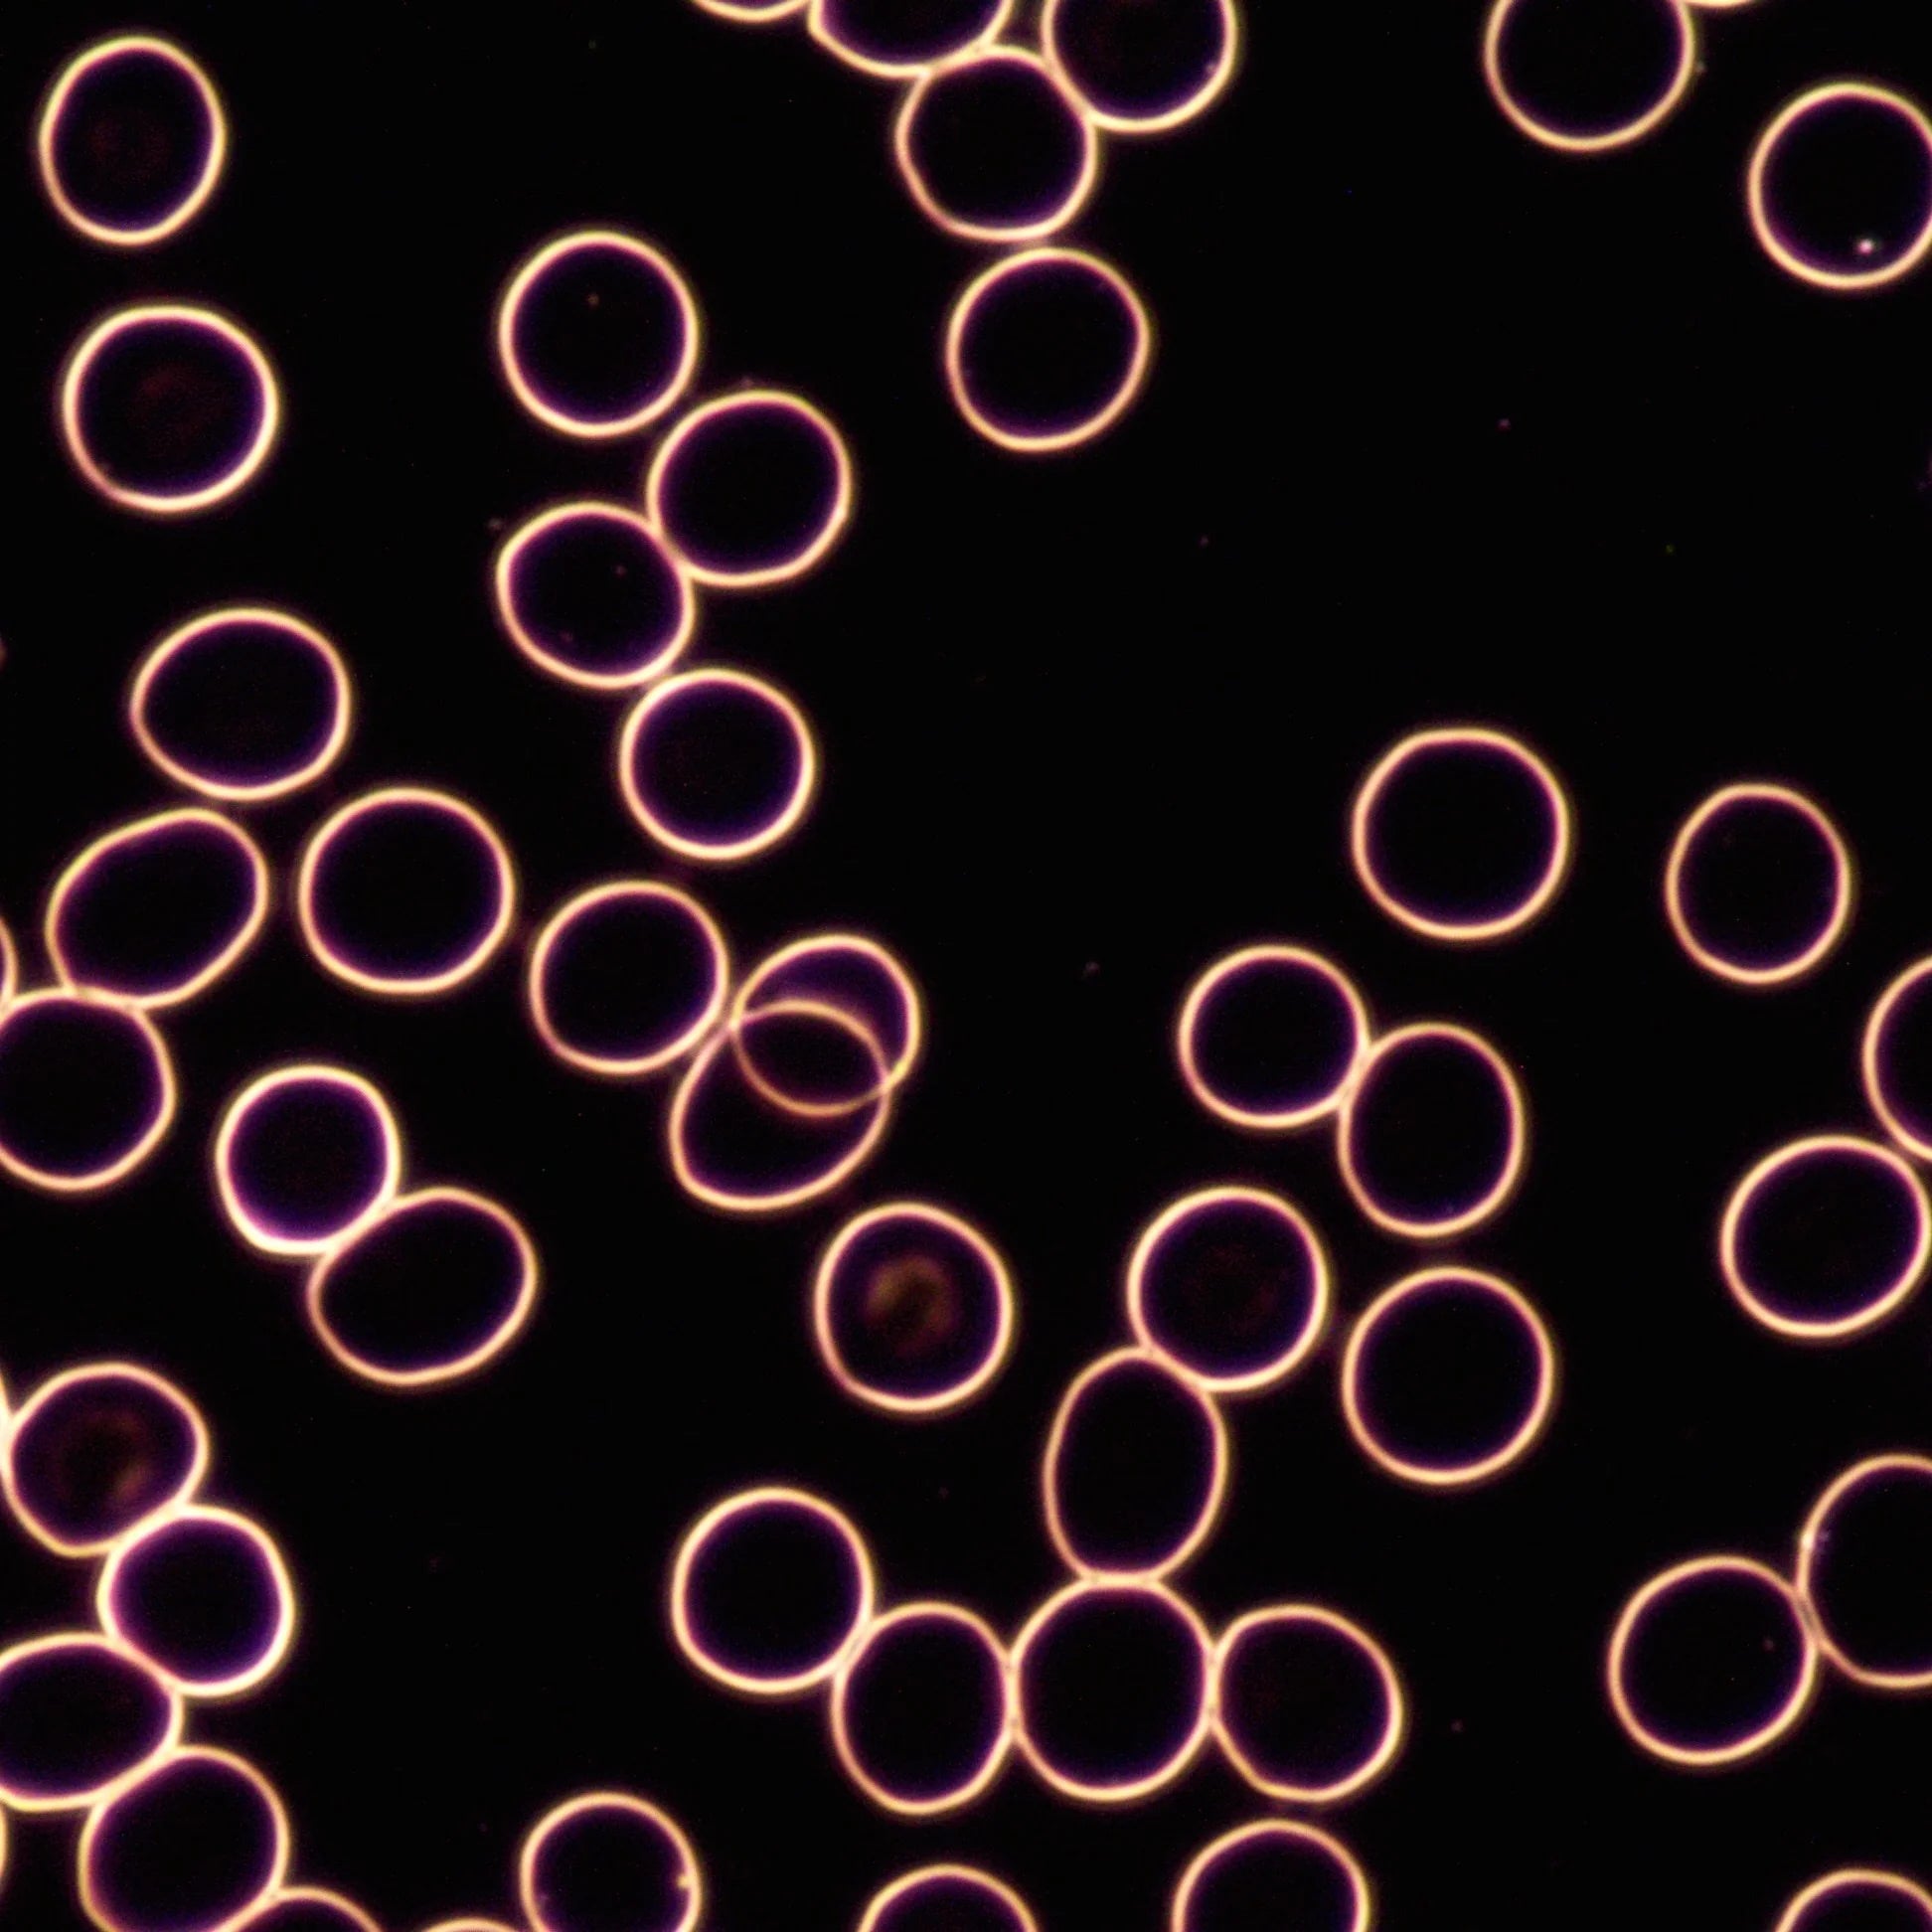

Microcell Sciences
Pleomorphic Sample
Regular price
$150.00 CAD
Regular price
Sale price
$150.00 CAD
Unit price
per


